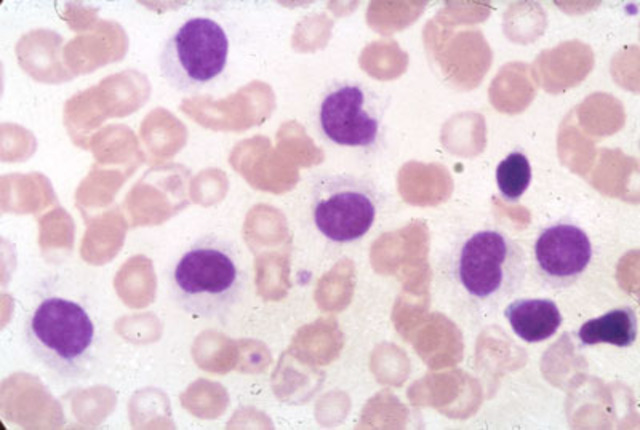
John Moore's Diagnosis

-
-
The United States of America pass the Plant Patent Act which allows plant breeders to patent new types of asexual plants.
-
The first human tumor cell line was developed by scientists after taking cervical cancer cells from Henrietta Lacks.
-
Dr Joseph E. Murray was the first surgeon to perform a successful organ transplant. His patient was Richard Herrick recieved one of his twin brother kidneys. Murray is often seen as the Pioneer of Organ Transplants
-
Dr Ananda Mohan Chakrabarty of General Electric in Schnectady New York sets out to develop a special kind of “bug” or bacteria that can eat crude oil
-
Moore visits the UCLA Medical center only to confirm the previous diagnosis that he has contracted an extremely rare form of cancer, hairy cell leukemia
-
Surgeons at UCLA medical center remove a portion of Moore's spleen where they end up storing and using it for research
-
Born in Great Britian, Louise Brown is the worlds first person conceived by means of In Vitro fertilization
-
The Oral argument was held before the Supereme court of the United States of America on the basis of wheter Chakrabarty can or cannot recieve the patent for the microbe he created.
-
The Supreme court of the United States of America by a Five to Four margin upheld the CCPA decision and granted Chakrabarty his Patent.
-
Stanley N. Cohen and Herbert W. Boyer are granted U.S. Patent 4,237,224 which gives them the right to gene cloning
-
Ronald Reagan is sworn in as the 40th President of the United States of America.
-
Dr Golde along with the Regents of the University of California apply for a patent on the cell line which was established from John Moore’s T lymphocytes
-
Developed by Genetech by genetically engineering bacteria for treating diabetes. Would be the first biotech drug to be approved by the Food and Drug Administration
-
Dr Golde and the Regents of the University of California are issued the patent for the cell line established from Moore’s T lymphocytes as well as the nine products derived from it
-
Approved by the U.S. Congress, it outlawed the sale of human organs and established the Organ Procurement and Transplantation Network (OPTN) to maintain a national registry for organ matching
-
The Food and Drug Administration approves Genentech first human pharmaceutical Protropin, a Human growth hormone for children with growth hormone deficiency to be developed and marketed.
-
United Nation For Organ Sharing has been the only oganization to manage the OPTN since its establishment in 1984
-
The PTO issued a ruling which extended the Chakrabarty ruling to include all multicellular organisms including animals.
-
The first Patent issued by the PTO for a transgenic animal
-
The California Court of Appeals reversed the lower lower court and held that John Moore had a property right in his own bodily tissues as well that he was entitled to a part ownership in the patented cell line which bore his name. Dr Golde and the Regents of the Universirty if California would appeal this case to the California Supreme Court
-
After two terms in office. President Ronald Reagan steps down.
-
Exxon uses oil eating bacteria as a method to help with the clean up effort.
-
The California Supreme Court ruled that human cells and tissues were not property and could not be sold or bartered by the person giving them up therefore Moore had no “property right” while granting that “property right” to the researchers or corporations.
-
The United States Department of Energy and the National Institutes of Health in the United States begin the Human Genome Project with the goals of providing a complete and accurate sequence of the 3 billion DNA base pairs that make up the human genome.
-
Jeff Getty an AID's patient and the first person to recieve a baboon to human bone marrow transplant which was performed successfully and extended his life.
-
Dolly was the first mammal to be cloned from another adult mammal. She was cloned at the Roslin Institute near Edinburgh In Scotland by Dr Ian Wilmut and his colleagues
-
In response to the large scale human cloning ethics debate brought by Ian Wilmut's announcement on the creation of Dolly. President Clinton proposes a 5 year moratorium on federal and privately funded human cloning research.
-
Researchers devised the first Aritificial Human Chromosome that survives 6 months
-
Following up on his proposal for a moritorium. President Clinton introduced this act with the intention of prohibiting for five years the use of Somatic Cell Nuclear Transfer Technology for the purpose of cloning a new human being.
-
Passed by the U.S. House of Representatives this act enacts complete ban on somatic cell nuclear transfer to create cloned human embryos; it threatens transgressors with criminal punishment and civil fines. Yet a vote on this act in the senate never occured so it died.
-
John Moore dies at the age of 56 in a Seattle hospital after undergoing a expiremental treatment for his leukemia.
-
Introduced to the U.S. House of Representatives it would prohibit "any person or entity, in or affecting interstate commerce, from knowingly: (1) performing or attempting to perform human cloning; (2) participating in such an attempt; (3) shipping or receiving an embryo produced by human cloning or any product derived from such an embryo; or (4) importing such an embryo." (Library of Congress)
-
At the age of 6 Dolly dies from a progressive lung disease
-
Though this legaslation was not acted or voted upon once it reached the senate so it simply died
-
Dr David W. Golde would be found dead in his apartment in Manhattan. He committed suicide.
-
Jeff Getty the first person to recieve bone marrow from a baboon died of heart failure after treatment for cancer and a long struggle with AID's
-
This act would prohibit or "make it unlawful for any person, including a governmental entity, to: (1) perform or attempt to perform human cloning; or (2) ship, mail, transport, or receive the product of human somatic cell nuclear transfer technology knowing that such product is for the purpose of human cloning. Sets forth criminal and civil penalties for violations of this Act." (LIbrary of Congress)
-
On a roll call vote, the Human Cloning Prohibition Act of 2007 fails to gain enough Yea's required to pass the House of Representatives
-
American Biologist and entrepreneur Craig Venter and his team create a strain of Mycoplasma mycoides called JCVI-syn1.0 with a synthetic genome which they have nicknamed "Synthia"
Want to make a timeline like this?
Use Timetoast to turn dates, events, milestones, and phases into a clear visual timeline you can build and share. Timetoast is a timeline maker for work, school, research, and stories.